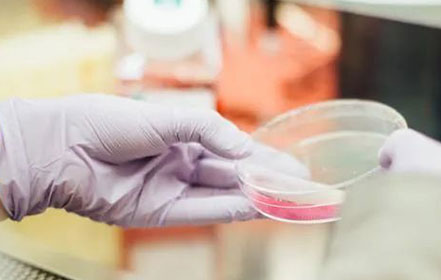

皓奇星 | 贏在CMC開發(fā)的起跑線-雙特性抗體CMC開發(fā)
皓陽生物基于可商業(yè)化授權的CHO-K1細胞株,結合自有的質粒系統(tǒng)以及細胞株篩選方案,建立皓越?穩(wěn)定細胞株平臺�����,2021年至今已為國內外客戶完成超過50個單抗����、雙抗以及融合蛋白穩(wěn)定細胞株構建項目�。在常規(guī)培養(yǎng)條件下,項目平均表達量大于6.7g/L��,高效助力客戶項目更快更好推進。2022年���,基于皓越?的基礎上進一步打造Fut8敲除的ADCC加強型穩(wěn)定細胞株構建平臺,為客戶提供更多元的選擇與服務�����。
2022 / 08 / 05
了解詳情 >>